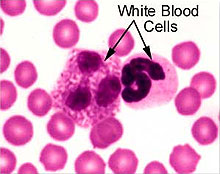

|
|
Complementary and Alternative Therapies for Leukemia
 A
comprehensive treatment plan for leukemia may
include a range of complementary and alternative therapies. A
comprehensive treatment plan for leukemia may
include a range of complementary and alternative therapies.
Standard medical treatment for leukemia
usually involves either chemotherapy, radiation therapy or both. There is no
evidence that anything but current medically approved standard therapy can stem
the progression of or cure these cancers. Therefore, standard therapy should not
be replaced by any unproven remedy.
Although standard treatment has greatly improved survival for individuals with
leukemia, the side effects can be difficult. There are certain complementary and
alternative therapies, which can be used in addition to the treatment prescribed
by their doctor.
Complementary therapies are those that are used in combination
with, or in addition to, the standard medical treatment prescribed
by your doctor. Complementary therapies are usually used to relieve
symptoms, alleviate pain or the side effects of standard cancer
treatment, and to improve overall physical, emotional, and spiritual
well-being. Alternative therapies are promoted for use instead of
the standard cancer treatment prescribed by your doctor. Any therapy
promoted for use instead of the standard medical treatment to fight
cancer is considered alternative.
|
Diet & Nutrition
 Eating
the following nutrient-dense foods that are high in
antioxidants may help protect against cancer: dark berries, orange and
yellow vegetables, dark leafy greens, fresh vegetable juices containing
wheatgrass, beets, romaine lettuce, parsley, and cucumber. Eating
the following nutrient-dense foods that are high in
antioxidants may help protect against cancer: dark berries, orange and
yellow vegetables, dark leafy greens, fresh vegetable juices containing
wheatgrass, beets, romaine lettuce, parsley, and cucumber.
Regularly consume yogurt, deep orange vegetables (carrots,
squash, sweet potatoes), vegetables in the cabbage family, tomatoes,
citrus fruit, and dark green leafy vegetables. Remember to go for
the color. The deeper the color of fruit or veggie, the more
nutrients.
|
Follow the Food Pyramid
A good way to help make sure you are following a healthy eating plan is to use
the USDA Food Pyramid as a
guide. The pyramid recommends six groups of food that you need to eat to promote
good health, and it lists them in descending order of the amounts you need to
eat every day. Following the pyramid means eating:
-
6-11 servings of breads and cereals, rice or pasta

-
2-4 servings of fruit
-
3-5 servings of vegetables
-
2-3 servings of meat, poultry, fish, dried beans, nuts and eggs
-
Sparing amounts of fats and oils for flavor
-
If you do use fat in your
diet, try to stick to monounsaturated fat from oil, canola and fish oils;
they all provide Omega-3 fatty acids, which are an important part of a
healthy diet.
-
 The
use of alcohol, even in moderate amounts, is associated with increased risk
for cancers of the mouth, larynx, pharynx, esophagus, liver, colon, rectum
and breast. Women at high risk for breast cancer might consider abstaining
from it altogether. There are no known protective effects of alcohol against
cancer to counterbalance the known cancer risks of moderate to heavy use. The
use of alcohol, even in moderate amounts, is associated with increased risk
for cancers of the mouth, larynx, pharynx, esophagus, liver, colon, rectum
and breast. Women at high risk for breast cancer might consider abstaining
from it altogether. There are no known protective effects of alcohol against
cancer to counterbalance the known cancer risks of moderate to heavy use.
-
Alfatoxins are naturally occurring poisons caused by molds during the
harvesting, shipment or storage of foods, particularly nuts, grains and
seeds. Always store these foods in sealed containers, and throw them away if
they become moldy.
-
 A
Zen macrobiotic diet which proceeds
through 10 dietary stages, until one eats only brown rice and water, is not
recommended for preventing cancer. (However, the more liberal version --
which includes whole grains, fish, nuts, seeds, tofu and vegetables -- is
quite consistent with dietary recommendations for preventing cancer.)
Macrobiotic diets of any kind should be avoided by people who have cancer
already, because they may not provide enough calories
and protein to protect against the wasting
effects -- or cachexia -- associated with cancer. A
Zen macrobiotic diet which proceeds
through 10 dietary stages, until one eats only brown rice and water, is not
recommended for preventing cancer. (However, the more liberal version --
which includes whole grains, fish, nuts, seeds, tofu and vegetables -- is
quite consistent with dietary recommendations for preventing cancer.)
Macrobiotic diets of any kind should be avoided by people who have cancer
already, because they may not provide enough calories
and protein to protect against the wasting
effects -- or cachexia -- associated with cancer.
-
 Foods
grilled at very high temperatures, especially fatty foods, should be
avoided. The smoke produced by the burning fat produces polycyclic aromatic
hydrocarbons (PAHs) which may be carcinogenic. You can reduce the negative
effects of grilling by trimming as much as possible from meats, skinning
poultry before broiling, and not putting frozen meats on the grill. Foods
grilled at very high temperatures, especially fatty foods, should be
avoided. The smoke produced by the burning fat produces polycyclic aromatic
hydrocarbons (PAHs) which may be carcinogenic. You can reduce the negative
effects of grilling by trimming as much as possible from meats, skinning
poultry before broiling, and not putting frozen meats on the grill.
-
 Smoked
foods tend to absorb carcinogens that are similar chemically to cigarette
tars in tobacco smoke. Smoked
foods tend to absorb carcinogens that are similar chemically to cigarette
tars in tobacco smoke.
-
 Salt-cured,
pickled and nitrite-cured foods may increase the risk of cancer. Salt-cured,
pickled and nitrite-cured foods may increase the risk of cancer.
Supplements
Potentially beneficial nutrient supplements include those listed below.
-
Vitamin A
(25,000 IU a day),
vitamin E
(800 IU a day),
vitamin C (3 to 6 g a day), and
selenium
(200 to 400 mcg a day) have antioxidant activity and may decrease side
effects of chemotherapy and radiation
-
Vitamin D
(400 to 800 IU a day) may help promote differentiation of cells
-
 B-complex
(50 to 100 mg a day) with additional B12 (1,200 mcg a day) and folic acid
(800 mcg a day) for anemia. B-complex
(50 to 100 mg a day) with additional B12 (1,200 mcg a day) and folic acid
(800 mcg a day) for anemia.
-
Coenzyme Q10 (CoQ10). CoQ10, an antioxidant and potential immune
stimulator, is sold in capsule form and is being studied in persons with
leukemia, and other cancers. Some results indicate that this therapy may be
useful as a complementary therapy, enhancing the immune system and providing
protection against the harmful effects of radiation and/or some chemotherapy
drugs on healthy tissues. On occasion, individuals taking this
supplement have experienced mild side effects
such as headache, heartburn, fatigue, diarrhea, and rash. CoQ10 is being
studied to further determine whether it is beneficial, whether it is safe,
and for whom.
Supplements should be taken with good food, not instead of good food.
Herbs
The use of certain herbal remedies may support the lymphatic system, spleen,
bone marrow, and liver. Take a combination of the following herbs in equal
parts, 30 to 60 drops three times a day.
-
Red clover (Trifolium pratense)
-
Blue flag (Iris versicolor)
-
Yellow Dock
(Rumex crispus); for late-stage
disease, substitute greater celandine
(Chelidonium majus) for yellowdock
-
Poke root (Phytolacca americana)
-
-
Cleavers (Galium aparine)
-
Cornflower
(Echinacea purpurea)
-
Turmeric (Curcuma longa) (250 to 500 mg two
to three times a day)
-
Periwinkle (Vinca rosea) and autumn primrose
(Colchicum officinale).
Note: these are potentially toxic herbs to consider for use only
under a supervising physician.
Herbs are generally available as dried extracts (pills, capsules, or
tablets), teas, or tinctures (alcohol extraction, unless otherwise noted). Dose
for teas is 1 heaping tsp./cup water steeped for 10 minutes (roots need 20
minutes).
Hoxsey- herbal formula
Purported to be an immune-boosting remedy, this herbal formula was
developed in the early 1900s to treat cancer and is now offered in
Tijuana. The formula, which may be used on the skin or taken as a
liquid, consists of agents such as bloodroot, arsenic sulfide,
sulfur, licorice, red clover, burdock root, barberry, cascara, and
other herbs. Advocates of this treatment say that it strengthens the
immune system and causes cancer cells to die. Side effects, such as
diarrhea, nausea and vomiting - and some more serious conditions -
have been observed with the ingredients used in the Hoxsey
treatment.
|
 Homeopathy Homeopathy
An experienced homeopath can prescribe a regimen for treating leukemia that is
designed especially for you. Acute remedies may be useful for relief of symptoms
associated with complications.
Homeopathic remedies are prescribed by symptoms rather than
conditions, as each case of a particular illness can manifest
differently in different people.
|
Acupuncture
 Developed
in China more than 2000 years ago, this is a complementary therapy that has been
studied thoroughly. Acupuncture is a technique which involves the placing of
needles into the skin at certain points, called meridians. This therapy has been
proven effective as a complementary therapy against general muscle pain and the
nausea and vomiting of chemotherapy. Developed
in China more than 2000 years ago, this is a complementary therapy that has been
studied thoroughly. Acupuncture is a technique which involves the placing of
needles into the skin at certain points, called meridians. This therapy has been
proven effective as a complementary therapy against general muscle pain and the
nausea and vomiting of chemotherapy.
Chinese herbs and acupuncture may be a powerful adjunct to conventional
therapy.
There is also some evidence that acupuncture may lessen the need
for conventional pain-relieving drugs.
|
Note: It is important to speak with your doctor about any complementary or
alternative therapies you are currently using or considering.
Related Links
|
|
|
|
|

 Homeopathy
Homeopathy
 Developed
in China more than 2000 years ago, this is a complementary therapy that has been
studied thoroughly. Acupuncture is a technique which involves the placing of
needles into the skin at certain points, called meridians. This therapy has been
proven effective as a complementary therapy against general muscle pain and the
nausea and vomiting of chemotherapy.
Developed
in China more than 2000 years ago, this is a complementary therapy that has been
studied thoroughly. Acupuncture is a technique which involves the placing of
needles into the skin at certain points, called meridians. This therapy has been
proven effective as a complementary therapy against general muscle pain and the
nausea and vomiting of chemotherapy.

A
comprehensive treatment plan for
A
comprehensive treatment plan for  Eating
the following nutrient-dense foods that are high in
Eating
the following nutrient-dense foods that are high in 
 The
use of alcohol, even in moderate amounts, is associated with increased risk
for cancers of the mouth, larynx, pharynx, esophagus, liver, colon, rectum
and breast. Women at high risk for breast cancer might consider abstaining
from it altogether. There are no known protective effects of alcohol against
cancer to counterbalance the known cancer risks of moderate to heavy use.
The
use of alcohol, even in moderate amounts, is associated with increased risk
for cancers of the mouth, larynx, pharynx, esophagus, liver, colon, rectum
and breast. Women at high risk for breast cancer might consider abstaining
from it altogether. There are no known protective effects of alcohol against
cancer to counterbalance the known cancer risks of moderate to heavy use.
 A
Zen
A
Zen  Foods
grilled at very high temperatures, especially fatty foods, should be
avoided. The smoke produced by the burning fat produces polycyclic aromatic
hydrocarbons (PAHs) which may be carcinogenic. You can reduce the negative
effects of grilling by trimming as much as possible from meats, skinning
poultry before broiling, and not putting frozen meats on the grill.
Foods
grilled at very high temperatures, especially fatty foods, should be
avoided. The smoke produced by the burning fat produces polycyclic aromatic
hydrocarbons (PAHs) which may be carcinogenic. You can reduce the negative
effects of grilling by trimming as much as possible from meats, skinning
poultry before broiling, and not putting frozen meats on the grill.  Smoked
foods tend to absorb carcinogens that are similar chemically to cigarette
tars in tobacco smoke.
Smoked
foods tend to absorb carcinogens that are similar chemically to cigarette
tars in tobacco smoke.  Salt-cured,
pickled and nitrite-cured foods may increase the risk of cancer.
Salt-cured,
pickled and nitrite-cured foods may increase the risk of cancer. 

